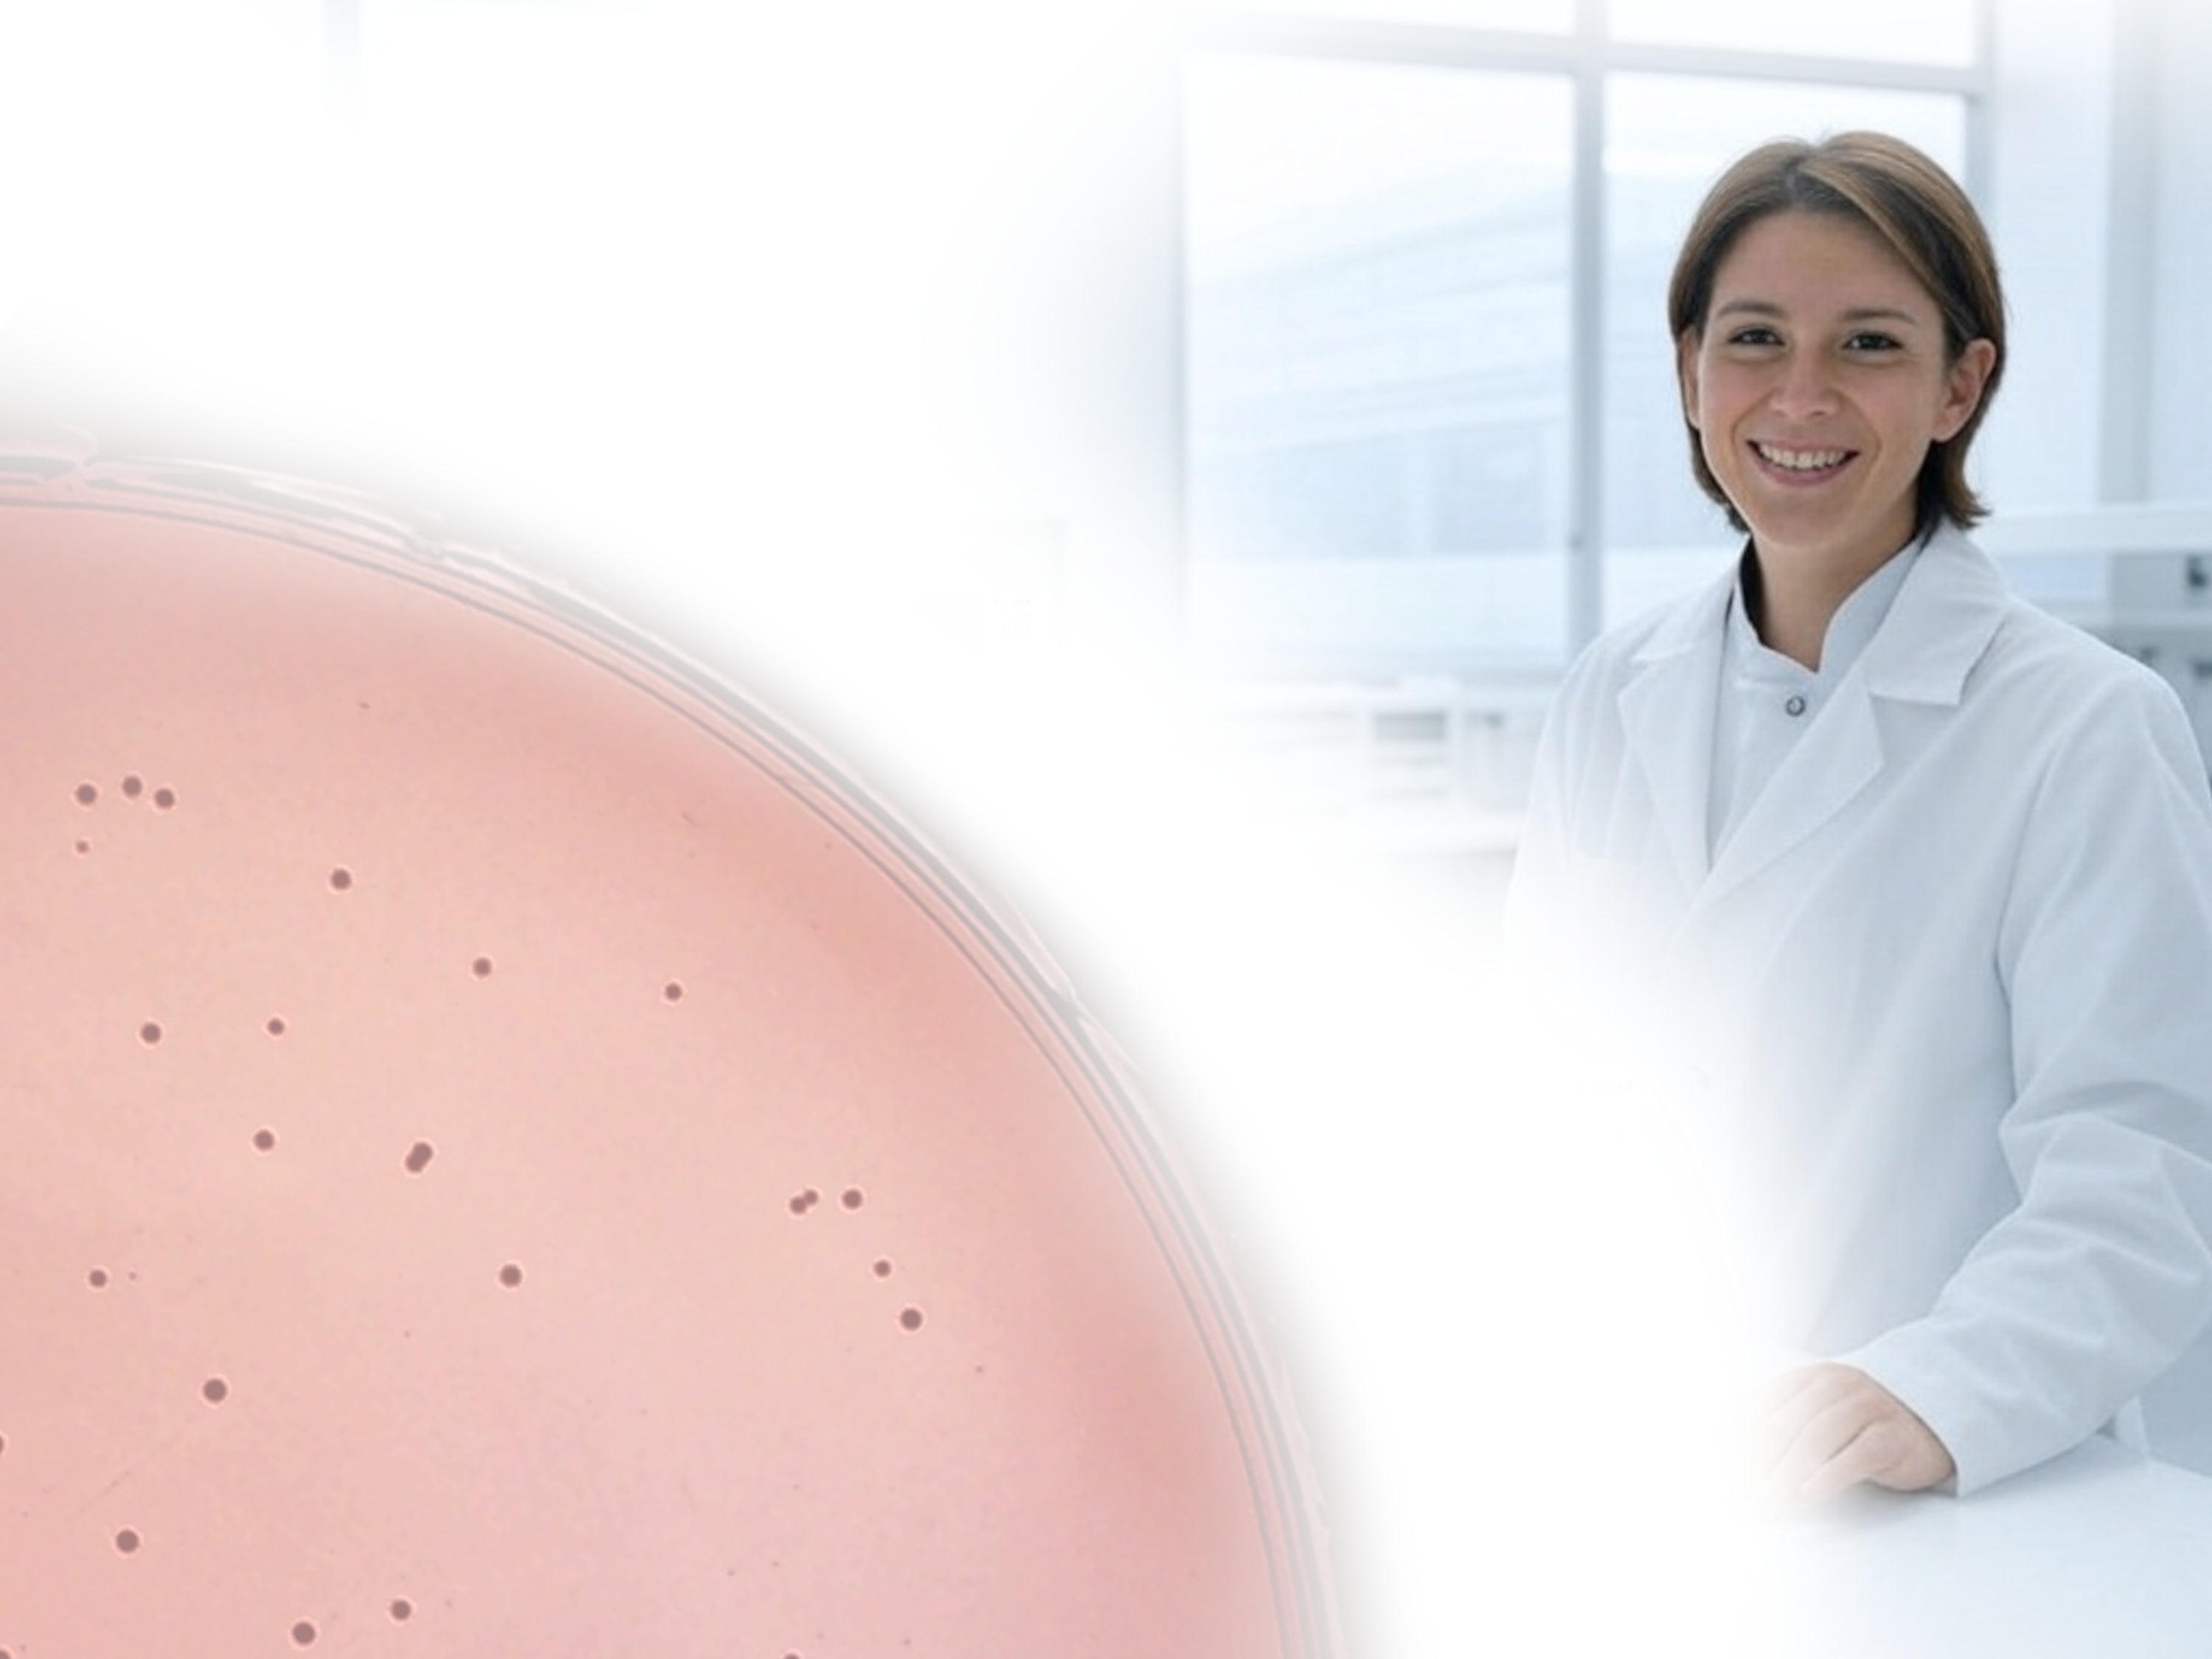

Automated Colony Counter System for Labs
Automated Colony Counter
Fast, precise CFU counting with AI-powered imaging and audit-ready data.
Automate bacterial your colony counts on standard 100mm Petri plates, Compact Dry, Petri Film, and Microfast with the high-resolution, AI-driven IncuCount. IncuCount software delivers fast, reproducible results while reducing manual error and ensuring 21 CFR Part 11 data integrity. When standardizing colony counts with automation, laboratories achieve greater consistency. Designed for the fields of food safety testing, pharmaceutical, environmental, and research, the IncuCount is ideal for both, high and low throughput.




Food Safety & Beverage Microbiology Testing
Automated colony counting and inhibition zone measurement for Petri dishes, CompactDry™, and Petrifilm™ plates. Helps food and beverage labs detect and document coliforms, yeasts, molds, and other common microorganisms with speed and consistency.
Pharmaceutical & Industrial Quality Control
Automates CFU counting and inhibition zone measurement to support routine quality control testing. With options for audit trails and LIMS export, results are more consistent and easier to manage compared to manual counting.
Environmental Microbiology
Supports colony counts and inhibition zone measurements for a wide range of agar plates. Useful for routine diagnostic plates, air filtration, water testing, wastewater monitoring, and environmental samples where consistent, digital records are needed.
Biotechnology & Research Applications
Provides researchers with automated tools for colony recognition, morphology studies, blue - white mutant detection and inhibition zone measurement. Suitable for academic microbiology labs, biotech R&D, and teaching environments where reproducibility and digital datasets matter.
Bacterial Colony Counter Made Colony Counting Simple
Why Choose Newlander?
AI-Powered Analysis
Advanced machine learning algorithms for precise colony detection
Rapid Processing
Analyze samples in seconds with our high-speed imaging technology
AMERICAN Manufacturer
Engineered for microbiology labs
21 CFR Part 11
Audit trail support for compliance and LIMS compatibility
Trusted by Labs
Food safety, pharma QC & biotech
Free Shipping
Free shipping for all orders in the USA
Satisfaction Guarantee
Simply return within 30 days if not satisfied
2 Year Warranty
Full coverage with manufacturer’s warranty
- Choosing a selection results in a full page refresh.